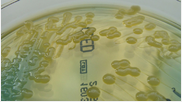

“比如在糖尿病、高血压等慢性病的用药方面,我们可以通过这样的方式让他减少来回医院的次数,减少患者的心理压力。”

当前,医药行业对生物类似药的前景非常看好。根据IMS机构近日发布的一份报告,在欧洲和美国,对生物类似物药物的扩大获取,将...

生物等效性研究证实,HIV三合一复方新药Odefsey(R/F/TAF)达到了与四合一HIV新药Genvoya(E/C/...

综上,移动医疗并未提供比传统医疗更多的销售假冒伪劣医疗器械和药品的机会,反而更易管理。当然如果药监连线下也管不好,遑论线...

诊后服务虽然看似一片“红海”,但真正能从医生的切实需求出发,以切实解决患者诊后随访为目标的产品还屈指可数。移动医疗的AP...

此次罗氏与Epizyme联手,将探索表观遗传学/免疫肿瘤学组合方案tazemetostat/Tecentriq的治疗潜力...

研究小组在两组不同的乳腺细胞系上进行测试。他们发现其中一种啤酒花物质——特别是6-异戊烯基柚皮素或称6-PN——能够增强...

所有这些步骤可以帮助控制血压,但是,单靠生活方式的改变是不够的。如果血压很高的话,应该积极配合药物进行降压治疗。

据8月14日发表在《美国医学会杂志》上的一则研究披露,在一个罹患心衰并接受心脏再同步治疗除颤器的人数众多的医疗保险投保人...
如今,微生物组和癌症之间的关联变得越来越明了,研究者们也在思考如何去调节病人i的微生物群落来改善患者对疗法的反应和预后情...

但是,像所有的超级竞争领域一样,会有赢家和输家。癌症公司如何在这个迅速发展的领域里计划和应对宏观战略问题将决定他们的命运...

细胞蛇是细胞生物学的新领域。多学科手段和尖端技术将加速我们对细胞蛇的系统理解。对细胞蛇的研究尚处于起步阶段。许多悬而未决...

Dravet综合征(Dravet syndrome,DS)又称婴儿严重肌阵挛性癫痫,是一种少见的主要由遗传因素引起的进行...

仅仅航班需要这样吗?小编认为,火车、客船等长途交通工具都可以借鉴学习这些做法这样给社会形成一种风气,医生就应该是非常值得...

当然摄入益生菌不仅可以直接帮助抵御癌症发生,还会增加机体中益生菌的水平,而靶向作用促癌细菌的抗生素或许也可以有效改善乳腺...
2026-02-06
2026-02-05
2026-02-05
2026-02-04
2026-02-04

